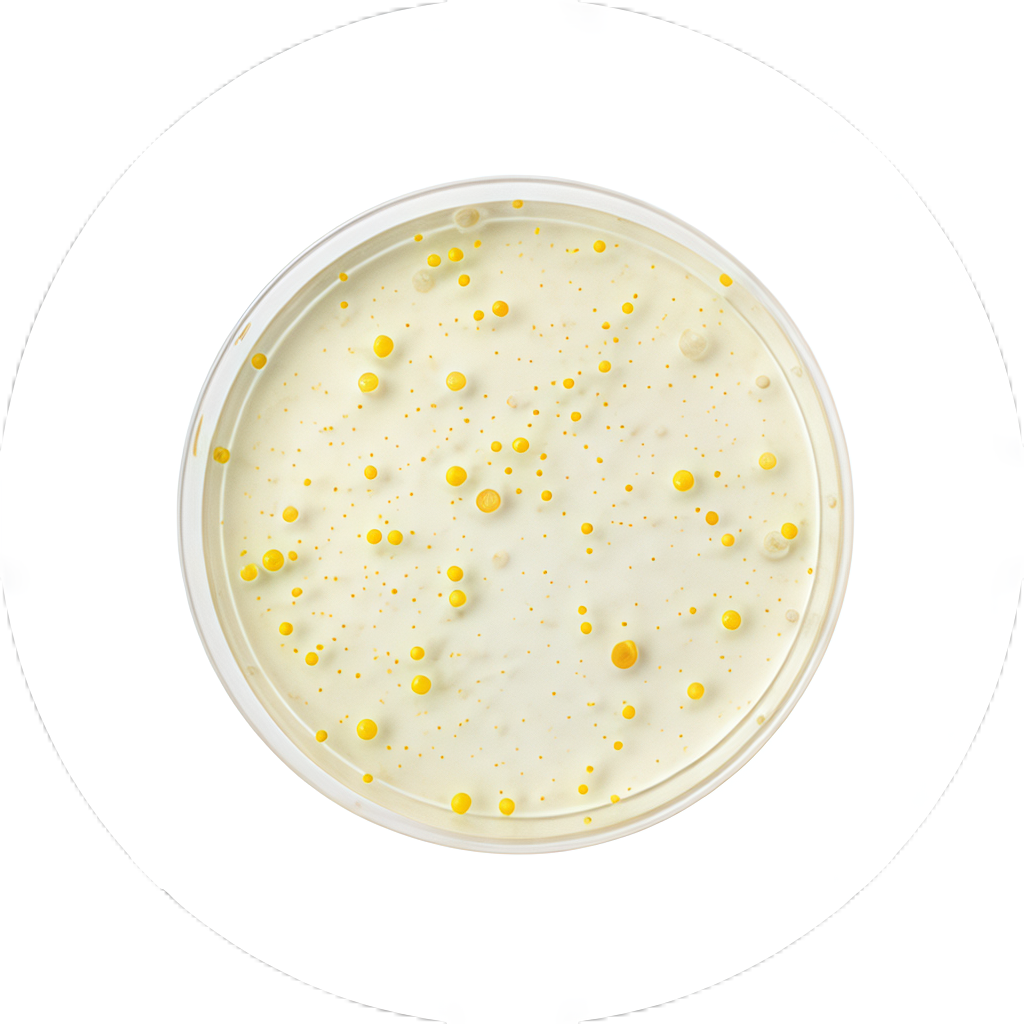

10% off for two tiems
15% off for three tiems
Free shipping over $90
10% off for two tiems
15% off for three tiems
Free shipping over $90
10% off for two tiems
15% off for three tiems
Free shipping over $90
10% off for two tiems
15% off for three tiems
Free shipping over $90
10% off for two tiems
15% off for three tiems
Free shipping over $90
10% off for two tiems
15% off for three tiems
Free shipping over $90
10% off for two tiems
15% off for three tiems
Free shipping over $90
10% off for two tiems
15% off for three tiems
Free shipping over $90
10% off for two tiems
15% off for three tiems
Free shipping over $90
10% off for two tiems
15% off for three tiems
Free shipping over $90
10% off for two tiems
15% off for three tiems
Free shipping over $90
10% off for two tiems
15% off for three tiems
Free shipping over $90
Key Ingredients

10 types of collagen in every scoop
While most collagen formulas on the market bring you only 1 or 2 types of collagen,our premium formula brings you 10 types of collagen from 4 real food sources. inaddition to types l, ll, lll, V and X, Multi Collagen Protein also has types IV, Vll, Vlll, Xll,XXll. Together, they build and support your joints, tendons, ligaments, skin, bones,muscles, hair, nails and gut and play a vital role in providing structural support to yourwhole body.

Clinically Studied Fermented Eggshell Membrane Collagen
We're the only leading collagen supplement brand on the market currently with aproprietary fermented eggshell membrane collagen ingredient backed by humanclinical studies to provide real results you can see and feel.

Easy-to-Absorb Vitamin C
The power of antioxidants delivered in a lipid metabolite form — easier for your body to absorb and retain for maximal benefits. Vitamin C also supports your body’s ability to produce collagen, which is why many of our formulas are enhanced with it.

Resilient SBO Probiotics
Nearly 100% of your gut lining is made up of collagen. That’s why we added soil-based probiotics to support healthy digestion and immune system function. Plus, our probiotics strains don't require refrigeration and can survive harsh environments that include higher temperatures and stomach acids.
Frequently Asked Questions
What is collagen?
What is collagen?
Collagen is the most abundant protein in our bodies, especially type I collagen. It’s found in muscles, bones, skin, blood vessels, tendons and the digestive system.
Collagen contains 18 different amino acids. Amino acids are the “building blocks of proteins,” and collagen includes a mix of both nonessential (also called conditional) and essential types.
What is the best way to mix this product?
What is the best way to mix this product?
Adults add one scoop of Multi Collagen Protein to 8 ounces of liquid using a blender, hand frother or shaker cup. You can even add a scoop to your favorite recipes including coffee, smoothies, pancakes, oatmeal, baked goods and other dishes. Head over to our store blog for more delicious ideas.
(Please note that Multi Collagen Protein is also made in small batches using real, whole-food ingredients. Natural variation between batches is normal, including mixability, taste, odor and color.)
Why does your packaging now say 10 types of collagen instead of 5 types of collagen?
Why does your packaging now say 10 types of collagen instead of 5 types of collagen?
Multi Collagen Protein is made with groundbreaking ingredients, including our clinically-studied fermented eggshell membrane collagen. That’s a newer ingredient in Multi Collagen Protein, backed by human clinical studies, and it’s shown to deliver fast results that truly last.
Because it’s a newer ingredient in our formula, there are studies and research released about it frequently. Recently, an analysis found even more collagen types in the eggshell membrane than we originally believed.
In addition to the types I, II, III, V and X, Multi Collagen Protein also has types IV, VII, VIII, XII, XXII. Together, those collagen types build and support your joints, tendons, ligaments, skin, bones, muscles, hair, nails, and gut.† They play a vital role in providing structural support to your whole body.
We have a team of experts who ensure that the research backs up our products and their benefits. So we’ll only communicate something if there is clear, definitive science showing it to be true. That’s why we’ve recently updated our Multi Collagen Protein to communicate ten types of collagen.
When should I use this product?
When should I use this product?
You can use this collagen powder in the morning, afternoon, evening or right before bed. There is no specific time to take collagen, but you’ll maximize benefits by taking it consistently. Find a time that works best for you to take it regularly.
What probiotic strain is featured?
What probiotic strain is featured?
Bacillus coagulans, which is a tough, effective strain of SBO or soil-based organism probiotics. We chose to use SBO probiotics because they're resistant to extremes in temperature as well as the harsh digestive tract, which helps them survive and thrive in your gut.
What does this collagen formula do?
What does this collagen formula do?
Scientific Studies Show that the Key Clinically Studied Fermented Eggshell Membrane Collagen Ingredient in Multi Collagen Protein: Promotes healthy hair thickness and growth, with a reduction in hair breakage† Improves the appearance of crow's feet after 4 weeks and skin tone after 8 weeks† Reduces knee stiffness at 7 days† Reduces knee stiffness, discomfort and improved function at 30 days† Reduces discomfort rapidly (7 days), continuously (30 days) and persistently (90 days)† Possibly reduces collagen degradation with noticeable results† Provides rapid relief for exercise-induced joint discomfort and stiffness† Supports healthy cartilage turnover† Helps joints recover faster from exercise-related joint stiffness and discomfort† Possibly helps reduce joint cartilage breakdown resulting from normal wear and tear† Helps protect joint cartilage from breakdown due to exercise† Helps reduce joint stiffness resulting from exercise† Helps support joint health and comfort† Reduces joint discomfort and stiffness† Reduces discomfort, both rapidly (7 days) and continuously (30 days)† Increases flexibility† Reduces range-of-motion-associated discomfort† Reduces knee discomfort and stiffness† Reduces discomfort, both rapidly (7 days) and continuously (60 days)† Improves immediate exercise-induced stiffness in as little as 7 days† Improves recovery from exercise-induced discomfort in as little as 8 days† Helps maintain healthy cartilage† Reduces the biomarker CTX-II, related to healthy cartilage† Lowers exercise-induced stiffness by 18%† Improves exercise recovery by 56%† Reduces exercise-induced stiffness and discomfort†
Can you explain what “collagen loading” is?
Can you explain what “collagen loading” is?
Our bodies are approximately 30% collagen, and most of us don’t consume enough collagen in our everyday diets. “Collagen loading” is when you consume up to three servings of collagen per day, most often from collagen powder or capsule supplements.
Collagen loading can help support our body’s production of collagen, which naturally declines as we age. It can help support healthy joints, digestion, bones, skin, hair, nails and more.
Of course, you should always consult your healthcare professional prior to beginning any new dietary or lifestyle regimen, including collagen loading.
Are your products produced in a facility with allergens?
Are your products produced in a facility with allergens?
We now have a disclaimer that is on ALL of our products and is being added to our website under the “Dietary Restrictions” section: "Produced on equipment that may also process peanuts, tree nuts, milk, soybean, wheat, sesame, shellfish, fish, egg." This is a voluntary disclaimer and our formulations have not changed.
Our manufacturers are required to have Policies and Procedures in place when it comes to handling and processing allergens. These allergen programs are in place to prevent cross contamination after each run by proper cleaning procedures. Allergen swab testing is also done after running an allergen containing product.
We test finished products for allergens prior to designating as “Free” of. We also follow cGMP (current good manufacturing practices) which guarantees allergen segregation.